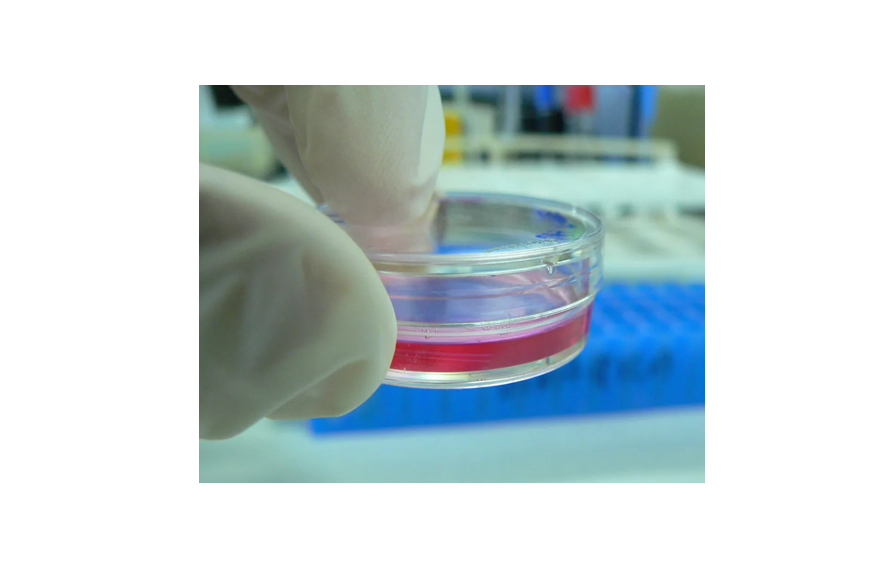

细胞培养基(cell culture medium)是人工模拟动物细胞的体内生长环境,维持体外细胞存活和增殖的营养物质基础,其主要功能是为细胞提供适宜的pH和渗透压,以及细胞本身不能合成的各种营养物质。
细胞培养基是盐、碳水化合物、维生素、氨基酸、代谢前体、生长因子、激素和微量元素的复杂混合物。不同细胞系对这些成分的要求各不相同,因此产生了不同类型的培养基。碳水化合物主要以葡萄糖的形式提供。
常用培养基
1、人多能干细胞培养基
应用于干细胞传代,内含干细胞保护因子,防止细胞的凋亡、分化,对细胞具有良好的保护作用。
(推荐产品:埃泽思AC-1001001 Advance人多能干细胞培养基)
2、人间充质干细胞培养基
应用于脐带、脂肪、骨髓、羊膜等不同组织来源的间充质干细胞分离与扩增。
(推荐产品:埃泽思AC-1001043 人脐带间充质干细胞无血清培养基)
3、RPMI-1640 Medium广泛应用于哺乳动物、特殊造血细胞、正常或恶性增生的白细胞,杂交瘤细胞的培养,主要用于悬浮细胞培养。
(推荐产品:埃泽思AC-1001104 RPMI1640培养基)4、Minimum Essential Medium(MEM)也称最低必需培养基,它仅含有12种必需氨基酸、谷氨酰胺和8种维生素。成分简单,可广泛适应各种已建成细胞系和不同地方的哺乳动物细胞类型的培养。
(推荐产品:埃泽思AC-1001098 MEM培养基)
5、DMEM-高糖(标准型)
可用于许多哺乳动物细胞培养,更适合高密度悬浮细胞培养。适用于附着性较差,但又不希望它脱离原来生长点的克隆培养,也可用于杂交瘤中骨髓瘤细胞和DNA转染的转化细胞的培养。
(推荐产品:埃泽思AC-1001099 DMEM培养基(高糖,HEPES不含丙酮酸钠))
6、DMEM-低糖(标准型)
可用于许多哺乳动物细胞培养。低糖适于依赖性贴壁细胞培养,特别适用于生长速度快、附着性较差的肿瘤细胞培养。
(推荐产品:埃泽思AC-1001101 DMEM培养基(低糖.含丙酮酸钠))
7、DMEM/F12适于克隆密度的培养。F12培养基成分复杂,含有多种微量元素,和DMEM以1:1结合,称为DMEM/F12培养基(DMEM/F12 medium),作为开发无血清配方的基础,以利用F12含有较丰富的成分和DMEM含有较高浓度的营养成分为优点。该培养基适用于血清含量较低条件下哺乳动物细胞培养。
(推荐产品:埃泽思AC-1001107 DMEM/F12培养基)
8、Iscove’s Modified Dulbecco Medium (IMDM)用于培养红细胞和巨噬细胞前体。此种培养液含有硒、额外的氨基酸和维生素、丙酮酸钠和HEPES。并用硝酸钾取代了硝酸铁。IMDM还能够促进小鼠B淋巴细胞,LPS刺激的B细胞,骨髓造血细胞,T细胞和淋巴瘤细胞的生长。IMDM为营养非常丰富的培养液,因此可以用于高密度细胞的快速增殖培养。
(推荐产品:埃泽思AC-1001102 IMDM培养基)
9、M-199 Medium主要用于鸡胚成纤维细胞培养。此培养液必须辅以血清才能支持长期培养。M-199可用于培养多种种属来源的细胞,并能培养转染的细胞。
(推荐产品:埃泽思AC-1001105 M199培养基)10、Ham’s F-12培养基
可以在加入很少血清的情况下应用,特别适合单细胞培养和克隆化培养,是无血清培养中常用的基础培养液。
(推荐产品:埃泽思AC-1001106 1X Ham's F12 培养基)
培养基体系主要成分及功能介绍葡萄糖:用于细胞能量代谢。
CO2:细胞需要少量的二氧化碳来维持生长。
在培养基中,溶解的CO₂与碳酸氢盐离子处于平衡状态,许多培养基利用了这种CO₂/碳酸氢盐反应来缓冲培养基的pH值。CO₂溶解在培养基中,与水反应生成碳酸。
酚红:用于监测培养基的pH值。
在细胞生长过程中,由于细胞释放的代谢物改变了pH值,培养基的颜色也随之改变。在较低的pH值下,酚红会变成中黄色,而在较高的pH值下,它会变成中紫色。对于大多数培养体系(pH为7.2 ~ 7.4),培养基应为鲜红色。(部分特殊培养基不添加酚红,例如对雌激素敏感的乳腺组织细胞,酚红会发挥跟类固醇相似的功能从而影响细胞。)
L-谷氨酰胺:
几乎是所有哺乳动物和昆虫细胞所必需的氨基酸,用于合成蛋白质,参与核酸代谢。它相比其他氨基酸更不稳定,容易降解,降解的速率和程度与储存温度、时间和pH值有关。
(推荐产品:埃泽思AC-1001078 L-谷氨酰胺(100X))
非必需氨基酸NEAA:
所有的培养基配方都含有10种必需氨基酸以及半胱氨酸、谷氨酰胺和酪氨酸。在一些培养基中还需要加入其他非必需氨基酸(丙氨酸、天冬酰胺、天冬氨酸、甘氨酸、谷氨酸、脯氨酸和丝氨酸)可以减少细胞的代谢负担,从而增加细胞增殖。
丙酮酸钠:
丙酮酸是糖酵解过程中的中间有机酸代谢物,可以轻易地进出细胞,可以为合成代谢过程提供能量来源和碳骨架。大多数培养基中丙酮酸钠的最终浓度为1mM,但在L-15培养基中增加到5mM,方便在无CO2环境中使用。

青霉素-链霉素(双抗生素)
用于预防细胞污染
(推荐产品:埃泽思AC-1001039 青霉素-链霉素溶液)
胰岛素
作为细胞培养的添加剂,可促进细胞增殖、延长细胞寿命,增加蛋白和核酸的表达量。
(推荐产品:埃泽思AC-1001079 重组人胰岛素溶液)
胰岛素-转铁蛋白-硒添加剂(ITS)
可降低多种细胞常规维持和低密度贴壁培养时所需的胎牛血清浓度。
地塞米松
一种抗炎糖皮质素,对细胞存活、细胞信号传导和基因表达具有一系列的影响。用于研究细胞凋亡、细胞信号传导通路和基因表达。
氢化可的松
促进表皮上皮细胞和乳腺上皮细胞增殖生长,提高神经胶质细胞和成纤维细胞的克隆形成率。
白细胞介素2(IL-2)
IL-2作为T细胞生长因子,可增强NK细胞的细胞溶解活性,并促进B细胞产生免疫球蛋白。常用于NK92细胞的培养。

添加剂通常制备为100×(或更高)的原液,分装储存。
添加剂可以改变培养基的渗透压,建议在加入添加剂后,重新检查渗透压,大多数脊椎动物细胞系的最佳渗透压位于260 - 320 mOSM/kg之间。
添加补剂后,完全培养基的有效期应根据实际情况来确定。
在-80℃或以下冷冻培养基会使一些生长因子和维生素从溶液中析出。即使加热到37℃,解冻后也很难让这些成分回到溶液中。建议将培养基避光储存在4℃。
每株细胞建议使用ATCC等数据库或原购买所推荐的培养体系,避免细胞因为培养基的改变,导致生长状态不佳、形态改变或分化等情况的发生。
培养基使用效果不佳:应定期确认培养基有效期,并确认是否使用细胞相应的培养基,培养基使用不当会影响细胞状态。
培养基使用时应储存于4℃并分装,避免反复升温加速谷氨酰胺的降解。
不同培养基由于成分不同,颜色也不尽相同,例如DMEM呈鲜红色,而MEM呈粉红色。
细胞培养过程中,可根据细胞培养基颜色变化,对培养状态进行分析,当培养基显著变橙色甚至黄色时,说明细胞代谢产生了大量酸性物质,需及时更换新鲜的完全培养基。
培养基开封,或者培养皿/瓶从培养箱中取出时,由于和空气发生气体交换,颜色会变为紫红色,放到CO2培养箱中即可恢复pH值,颜色变为正常的鲜红色。

AC-1001001 Advance人多能干细胞培养基
* 与mTesR体系对标,细胞增殖与形态无差异;
* 无需滋养层细胞;
* 营养更丰富,适用于大多数细胞系培养,且适用重编程过程细胞培养;
* 成分明确,批间差异小;
* 无外源动物成分,降低各类病毒、霉菌和支原体等的污染风险。

AC-1001043/AC-1001043PRF
人脐带间充质干细胞无血清培养基/(无酚红)
* 专为脐带间充质干细胞分离与扩增优化,传代稳定性高,最高可达20代;
* 全程无血清生产,极大降低批次间差异;
* 可用于原代分离,且培养过程无需包被培养板;
* 无外源动物成分,大大降低各类病毒、霉菌和支原体等的污染风险;
* 低热源,内毒素水平<0.12EU/mL,适用于细胞治疗应用。

AC-1001039 青霉素-链霉素溶液
* 使用细胞培养级水配制,无重金属离子以及其他杂质
* 0.1um 过滤,无细菌,无真菌,无支原体
* 内毒素<0.06EU/ml,远低于中国药典水平
埃泽思其他产品推荐

Xeno-Free人间充质干细胞培养基 AC-1001003
Xeno-Free人间充质干细胞培养基(无酚红) AC-1001003(PRF)
人脂肪干细胞无血清培养基(无酚红) AC-1001042(PRF)
PSC温和消化酶 AC-1001004
无血清细胞冻存液(治疗级) AC-1001006
评论列表